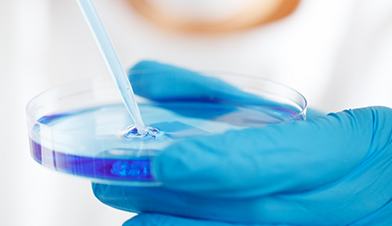

010-64653636

源自非洲原始部落
专注疑难创伤的奇愈力量

源自非洲原始部落
专注疑难创伤的奇愈力量
010-64653636

从原始部落的神秘圣药到如今呈现在您面前的七予膏,我们始终敬畏自然,相信奇愈力量
升级现有非洲原料保护基地,注入全球生物科研力量致力于多元化产品研发,令您不再因伤而伤

专注于疑难创伤的快速奇愈方案,终结久治不愈,开启生命新肌


公元2世纪初,位于西部非洲的一个原始神秘部落的酋长偶然发现当地特有植物和提取的植物油脂混合后对外伤有着特殊的修复能力。后经多次配制与人体实验,成为一种对于身体表面部位创伤具有神奇治愈效果的秘方,而此秘方一直在历代部落酋长中秘传… …
了解更多疑难创伤 神奇治愈
见效期短 快速愈合
遇见新肌 宛若新生